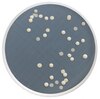

PVC504700 MilliporePVC Membrane Filter
Recommended Products
Overview
| Replacement Information |
|---|
| References |
|---|
| Product Information | |
|---|---|
| HS Code | 8421 22 00 |
| Filter Code | PVC5 |
| Filter Color | White |
| Maximum Operating Temperature | 100 °C |
| Filter Type | Screen filter |
| Applications | |
|---|---|
| Application | , 5.0 µm pore size, 47 mm diameter, hydrophobic PVC, white, plain |
| Contaminant of Interest |
|
| Regulated Test Method Number |
|
| Biological Information | |
|---|---|
| Wettability | Hydrophobic |
| Physicochemical Information | |
|---|---|
| Pore Size | 5.0 µm |
| Air Flow Rate | 2.9 L/min x cm² |
| Porosity % | 80% |
| Dimensions | |
|---|---|
| Filter Surface | Plain |
| Thickness | 50 µm |
| Filter Diameter (⌀) | 47 mm |
| Materials Information | |
|---|---|
| Chemistry |
|
| Toxicological Information |
|---|
| Safety Information according to GHS |
|---|
| Safety Information |
|---|
| Product Usage Statements |
|---|
| Storage and Shipping Information |
|---|
| Packaging Information | |
|---|---|
| Material Size | 100 |
| Transport Information |
|---|
| Supplemental Information |
|---|
| Specifications |
|---|
| Global Trade ITEM Number | |
|---|---|
| Catalogue Number | GTIN |
| PVC504700 | 04053252267499 |